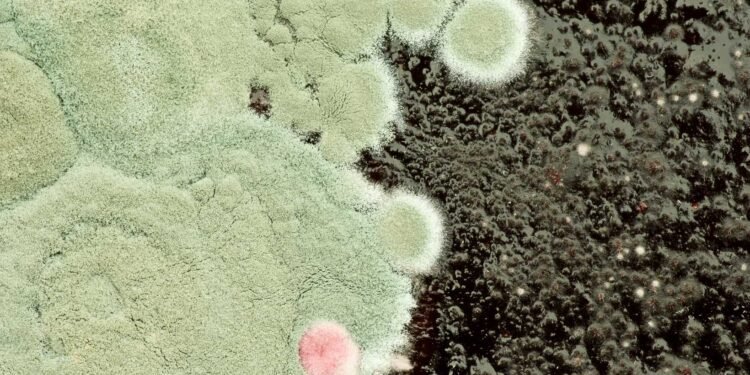
Aspergillosis Explained: Types, Symptoms, and Who's at Risk

Aspergillosis is a type of fungal infection caused by the Aspergillus fungus. This fungus is found in the environment around us and can be easily breathed in. Most people’s bodies can eliminate the fungus without causing any harm, but individuals with weakened immune systems or chronic lung disease may be at a higher risk of developing aspergillosis.

There are several types of aspergillosis, including allergic bronchopulmonary aspergillosis (ABPA), chronic pulmonary aspergillosis (CPA), and invasive aspergillosis. The symptoms of aspergillosis can vary depending on the type and severity of the infection, but may include coughing, wheezing, shortness of breath, fever, and chest pain.
Understanding the types, symptoms, and risk factors of aspergillosis is important for individuals who may be at higher risk of developing the infection. By recognizing the signs of aspergillosis and seeking prompt medical attention, individuals can receive appropriate treatment and manage the condition effectively.
Key Takeaways
- Aspergillosis is a type of fungal infection caused by the Aspergillus fungus.
- There are several types of aspergillosis, including ABPA, CPA, and invasive aspergillosis.
- Individuals with weakened immune systems or chronic lung disease may be at a higher risk of developing aspergillosis.
Understanding Aspergillosis
What is Aspergillosis?
Aspergillosis is an infection caused by a type of mold called Aspergillus. Aspergillus is a common type of fungus that can be found both indoors and outdoors. Most people breathe in Aspergillus spores every day without getting sick. However, people with weakened immune systems or lung diseases are more susceptible to developing aspergillosis.
Different Types of Aspergillosis
There are several different types of aspergillosis, including:
-
Allergic bronchopulmonary aspergillosis (ABPA): This type of aspergillosis occurs when the immune system overreacts to Aspergillus spores, causing inflammation in the lungs. Symptoms of ABPA include wheezing, coughing, and shortness of breath.
-
Chronic pulmonary aspergillosis (CPA): CPA is a long-term infection that affects people with pre-existing lung conditions, such as emphysema or tuberculosis. Symptoms of CPA include coughing, weight loss, and fatigue.
-
Invasive aspergillosis: This is the most serious type of aspergillosis and occurs when the Aspergillus mold invades the body’s tissues and organs. Invasive aspergillosis mainly affects people with weakened immune systems, such as those undergoing chemotherapy or organ transplant recipients.
-
Aspergilloma: This is a ball of fungus that can form in the lungs of people with pre-existing lung conditions, such as tuberculosis or sarcoidosis. Aspergillomas can cause symptoms such as coughing up blood and chest pain.
It is important to note that not everyone who is exposed to Aspergillus will develop aspergillosis. However, people with weakened immune systems or pre-existing lung conditions should be aware of the risks and take precautions to minimize their exposure to Aspergillus spores.
Causes and Risk Factors
Aspergillosis is caused by a type of fungus called Aspergillus, which is commonly found in soil, compost piles, and dead leaves. When inhaled, the spores of the fungus can cause infection in the lungs and other organs.
Who’s at Risk?
People with weakened immune systems are at a higher risk of developing aspergillosis. This includes individuals with HIV/AIDS, cancer patients undergoing chemotherapy or radiation therapy, and those who have undergone a transplant. Additionally, people who take corticosteroids or other immunosuppressive medications are also at an increased risk of developing the infection.
Age is also a factor, as older adults are more susceptible to aspergillosis due to a weakened immune system.
Environmental Exposure
Exposure to moldy environments can also increase the risk of developing aspergillosis. This includes working in occupations such as farming or construction where there is exposure to soil and other organic materials. People who spend a lot of time outdoors, especially in wooded areas, may also be at risk of exposure to Aspergillus spores.
It is important to note that not everyone who is exposed to Aspergillus spores will develop aspergillosis. However, those who are at a higher risk should take precautions to minimize their exposure to the fungus. This may include wearing a mask when working in dusty environments or avoiding areas with high concentrations of mold.
Signs and Symptoms
Aspergillosis symptoms can vary depending on the type of infection and which organs are affected. Here are some of the most common symptoms:
Common Symptoms
- Fever: A low-grade fever is a common symptom of aspergillosis. It may persist for several weeks or months and may come and go.
- Cough: A dry cough is another common symptom. It may be persistent and worsen over time. In some cases, coughing up blood may occur.
- Shortness of breath: Aspergillosis can cause shortness of breath, which may worsen over time. It may be accompanied by wheezing or chest tightness.
- Mucus: Thick, sticky mucus may be produced by the lungs, sinuses, or other affected areas.
- Fatigue: Aspergillosis can cause extreme fatigue, even with minimal activity.
- Joint pain: Joint pain and stiffness may occur in some cases.
Severe Cases
In severe cases of aspergillosis, the following symptoms may occur:
- Chest pain: Chest pain may occur due to inflammation of the lungs or other affected areas.
- Chest X-ray: A chest X-ray may show signs of inflammation, fluid buildup, or other abnormalities in the lungs.
- Difficulty breathing: Severe cases of aspergillosis can cause difficulty breathing, which may require hospitalization and oxygen therapy.
It is important to note that not all people with aspergillosis will experience these symptoms. Some people may have no symptoms at all, while others may experience more severe symptoms. If you are experiencing any of these symptoms, it is important to consult a healthcare professional for an accurate diagnosis and treatment plan.
Diagnosis of Aspergillosis
Aspergillosis can be difficult to diagnose since its symptoms look similar to many other illnesses. A healthcare provider considers the patient’s medical history, risk factors, symptoms, physical examinations, and lab tests when diagnosing aspergillosis.
Diagnostic Tests
Imaging tests like chest x-rays or CT scans of the lungs or other parts of the body may be needed depending on the location of the suspected infection. Sputum, blood, and tissue samples may also be tested to identify the presence of the Aspergillus fungus.
Cultures of the fungus can be grown from the samples and examined under a microscope to confirm the diagnosis. Antibody testing can also be done to detect the presence of Aspergillus-specific antibodies in the blood.
Interpreting Results
Interpreting the results of diagnostic tests for aspergillosis can be challenging. False negatives are possible, especially in cases of chronic pulmonary aspergillosis, which can mimic other respiratory diseases. False positives are also possible, especially in cases of allergic bronchopulmonary aspergillosis, which can mimic asthma or chronic obstructive pulmonary disease.
In conclusion, a combination of diagnostic tests is often needed to diagnose aspergillosis accurately. A healthcare provider with experience in diagnosing and treating fungal infections should be consulted if aspergillosis is suspected.
Treatment Options

There are several treatment options available for aspergillosis, including medications and surgical interventions. Treatment options depend on the type and severity of the infection.
Medications
Antifungal medications are the primary treatment for aspergillosis. The most commonly used antifungal medication is voriconazole, which is taken orally. Other antifungal medications that may be used include lipid amphotericin formulations, posaconazole, isavuconazole, itraconazole, caspofungin, and micafungin.
In some cases, oral corticosteroids may be prescribed to reduce inflammation in the lungs. However, corticosteroids should be used with caution as they can weaken the immune system and increase the risk of infection.
Surgical Interventions
Surgery may be necessary to remove aspergillomas or to treat invasive aspergillosis. In some cases, embolization may be used to block the blood supply to the aspergilloma before surgery.
Liver damage is a potential side effect of antifungal medications, particularly amphotericin B. Patients taking antifungal medications should be monitored for signs of liver damage, such as jaundice, abdominal pain, and nausea.
Patients should also be aware of potential drug interactions with antifungal medications, particularly with medications that are metabolized by the liver.
Overall, treatment for aspergillosis should be tailored to the individual patient and their specific condition. It is important to work closely with a healthcare provider to determine the best treatment plan.
Managing Complications

Aspergillosis can lead to severe complications, including lung damage, lesions, cavities, and bleeding. In some cases, the infection can be life-threatening, especially in individuals with weakened immune systems. Therefore, it is essential to manage the complications effectively to prevent further damage and ensure a speedy recovery.
Dealing with Severe Cases
Severe cases of aspergillosis may require hospitalization and intensive care. Treatment may include antifungal medication, oxygen therapy, and surgery to remove the infected tissue. Invasive aspergillosis, in particular, requires prompt treatment, as it can spread rapidly and cause damage to multiple organs.
In some cases, the patient may need to be placed on a ventilator to help them breathe. The healthcare team will monitor the patient’s vital signs and adjust the treatment plan accordingly. It is crucial to follow the doctor’s instructions carefully and attend all follow-up appointments.
Preventing Further Damage
Preventing further damage is crucial in managing aspergillosis complications. The patient should avoid exposure to mold and other environmental triggers that can exacerbate the symptoms. They should also practice good hygiene, including washing their hands regularly and avoiding contact with sick individuals.
In addition, the patient should follow a healthy lifestyle, including eating a balanced diet, getting regular exercise, and getting enough sleep. It is also essential to manage any underlying health conditions, such as asthma or cystic fibrosis, that can increase the risk of aspergillosis.
In conclusion, managing aspergillosis complications requires prompt and effective treatment, along with lifestyle changes to prevent further damage. With proper care and management, patients can make a full recovery and reduce the risk of recurrence.
Prevention Strategies

Aspergillosis is a fungal infection that can be prevented by taking certain measures to reduce exposure to Aspergillus. The following are some prevention strategies that can help reduce the risk of Aspergillosis:
Reducing Exposure
Aspergillus is a common fungus found in the environment, and it can be found in soil, decaying vegetation, and even in the air. People who are at risk of developing Aspergillosis should take precautions to reduce their exposure to the fungus. This includes avoiding areas where there is a lot of dust, such as construction sites, and avoiding contact with soil or compost.
Protective Measures
To protect against Aspergillosis, it’s important to wear protective gear such as gloves and masks when handling materials that may be contaminated with Aspergillus, such as soil, compost, or decaying vegetation. Gloves should be worn when handling soil, moss, or manure. Masks should be worn when working in dusty environments, such as construction sites.
Air filters can also be used to reduce the amount of Aspergillus in the air. HEPA filters are recommended for use in areas where people are at risk of developing Aspergillosis, such as hospitals or homes with people who have weakened immune systems.
In conclusion, prevention is key when it comes to Aspergillosis. By taking the necessary precautions to reduce exposure to Aspergillus, people can reduce their risk of developing this fungal infection.
Living with Aspergillosis
Living with Aspergillosis can be challenging, but with proper care and management, patients can lead fulfilling lives. The following subsections provide information on how patients can manage chronic conditions and maintain their quality of life.
Chronic Conditions
Aspergillosis can be a chronic lung condition that requires ongoing management. Patients may experience symptoms such as shortness of breath, coughing, and wheezing. In some cases, patients may require the use of steroids to manage their symptoms.
Patients with chronic Aspergillosis should work closely with their healthcare provider to develop a treatment plan that works for them. This may include medication, pulmonary rehabilitation, and other therapies.
Quality of Life
Living with Aspergillosis can impact a patient’s quality of life. Patients may experience limitations in their daily activities, such as difficulty breathing during exercise or other physical exertion. Additionally, patients may experience anxiety or depression related to their condition.
To maintain their quality of life, patients should seek support from their healthcare provider and loved ones. This may include counseling, support groups, and other resources that can help patients manage their condition and improve their overall well-being.
Overall, living with Aspergillosis requires ongoing management and support. Patients should stay informed about their condition and work closely with their healthcare provider to develop a treatment plan that meets their needs. With proper care, patients with Aspergillosis can lead fulfilling lives.
Frequently Asked Questions
What are the common symptoms indicating a possible Aspergillosis infection?
The symptoms of Aspergillosis can vary depending on the type of infection. Some common symptoms include coughing, shortness of breath, chest pain, fever, and fatigue. Allergic reactions to Aspergillus can cause wheezing, coughing, and other respiratory symptoms. Aspergillomas, which are fungal balls that form in the lungs, can cause coughing up of blood, wheezing, and shortness of breath.
What treatment options are available for Aspergillosis?
Treatment for Aspergillosis depends on the severity of the infection and the type of Aspergillosis. Antifungal medications are the most common treatment option for Aspergillosis. In some cases, surgery may be necessary to remove fungal balls or damaged lung tissue.
How is Aspergillosis diagnosed?
Aspergillosis is diagnosed through a combination of medical history, physical examination, and diagnostic tests. These tests may include blood tests, imaging tests such as chest X-rays or CT scans, and a biopsy of affected tissue.
Who is most at risk for contracting Aspergillosis?
People with weakened immune systems, chronic lung diseases, and those who have had organ transplants are at a higher risk of developing Aspergillosis. People who work in agriculture or construction may also be at a higher risk due to exposure to Aspergillus in the environment.
In which environments is Aspergillus commonly found?
Aspergillus is a common fungus that can be found in many different environments, including soil, plant matter, and decaying organic matter. It can also be found indoors in damp environments such as bathrooms, kitchens, and basements.
Are there different types of Aspergillosis, and how do they vary?
Yes, there are different types of Aspergillosis, including allergic bronchopulmonary Aspergillosis (ABPA), chronic pulmonary Aspergillosis (CPA), and invasive Aspergillosis. Each type of Aspergillosis has different symptoms and treatment options. ABPA is an allergic reaction to Aspergillus that affects the lungs and can cause respiratory symptoms. CPA is a chronic lung infection that can cause symptoms such as coughing and shortness of breath. Invasive Aspergillosis is a serious infection that can affect multiple organs and is often life-threatening.